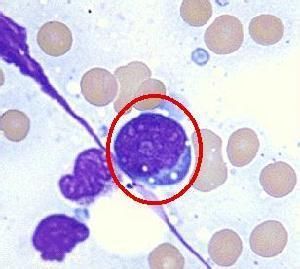
反應性

反應性的變化
溫度效應
反應性因反應堆溫度效應變化而引起的ρ發生變化的效應,稱為反應性的溫度效應。
溫度效應可以用反應性溫度係數來衡量。
負的溫度係數對於反應堆安全運行有重要意義。
中毒效應
熱中子反應堆運行後堆內參數的某些裂變產物,其中子吸收截面較大,故對ρ有明顯影響,這種效應稱為裂變產物中毒。
其中氙(135Xe)和釤(149Sm)是裂變產物中影響最大的兩種同位素。
燃耗
反應堆運行後會帶來燃料的損耗即燃耗,燃耗會帶來剩餘反應性的下降,這種效應稱為反應性燃耗效應,
控制
按照控制的目的可以分為:
1、調節控制
2、緊急控制
3、補償控制
按照控制的手段可以分為:
1、控制棒控制
2、化學補償控制
3、可燃毒物控制